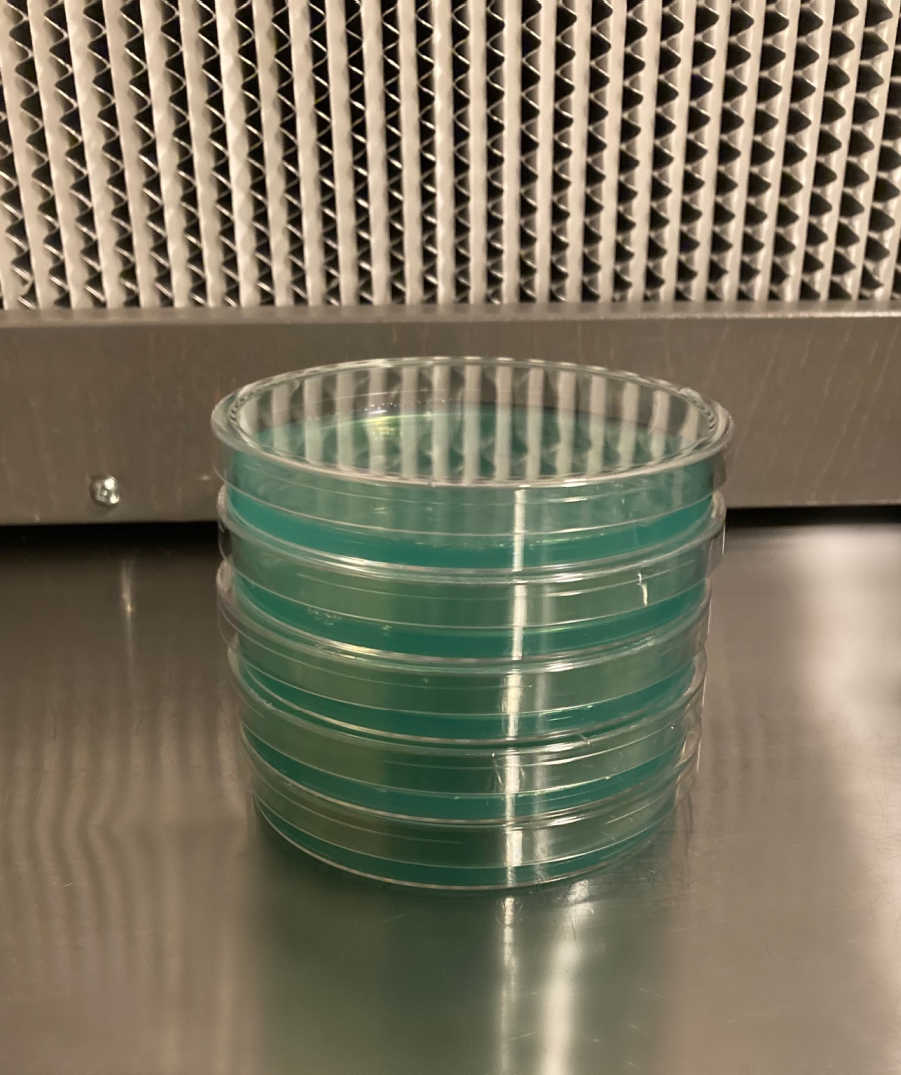
Pre-Poured Sterilized Malt Extract Agar Plates (5-Pack)

Pre-Poured Sterilized Malt Extract Agar Plates (5-Pack)
Pre-Poured Sterilized Malt Extract Agar Plates (5-Pack) is backordered and will ship as soon as it is back in stock.
Couldn't load pickup availability
Description
Description
Pre-Poured Sterilized Malt Extract Agar Plates (5-Pack)
Freshly Made Daily · Assorted Colors · Contamination-Resistant
Discover the key to reliable mycelium growth with our Sterilized Malt Extract Agar (MEA) Plates. Each 5-pack is freshly poured and sealed the same day, ensuring unmatched freshness and potency for all your mushroom isolation, transfer, and culture work.
Crafted with a perfectly balanced nutrient blend—including agar, malt extract, locust bean gum, and yeast extract—these plates are designed to support vibrant, healthy mycelium colonies from the very first transfer. Unlike store-bought agar that sits on shelves for weeks, we pour ours fresh daily and seal them in polyolefin packaging to lock in freshness.
What Makes Our MEA Plates Exceptional?
- 5 Sterilized MEA Plates per pack
- Crafted with a premium blend for optimal mycelial growth
- Microppose 90mm Polystyrene Petri Dishes – durable and professional-grade
- Chloramphenicol added to help resist bacterial contamination
- Machine poured in a laminar flow hood for maximum consistency
- Color-coded plates – helps track freshness and adds visual flair
- Store in the refrigerator and use within 3–4 weeks for best results
Lab-Poured Precision, Every Time
Starting April 2025, all plates are machine-poured in our clean room using advanced MediaPrep and MediaFill systems:
- Sterilized at 18 PSI for 30 minutes
- Dispensed at 25ml per plate
- Passed through UV-C sterilization, capped, and laser-labeled for accuracy
What Is Agar? How Do I Use It?
Agar is a vital tool in modern mycology. Just add a drop of spore solution to your plate and incubate. Within days, white patches of mycelium will emerge, allowing you to select the most vigorous and rhizomorphic growth. Once you’ve chosen a promising culture, simply cut a section and transfer it to a grain jar, spawn bag, or liquid culture.
Using agar allows you to:
- Identify and isolate clean, strong genetics
- Remove contaminants from spore samples
- Promote faster and more consistent results
Whether you’re a seasoned mycologist or just starting out, fresh MEA plates are an essential foundation for successful mushroom cultivation.
Learn more about using Agar by clicking Here
Watch this video on using Agar and Agar Slants Here!